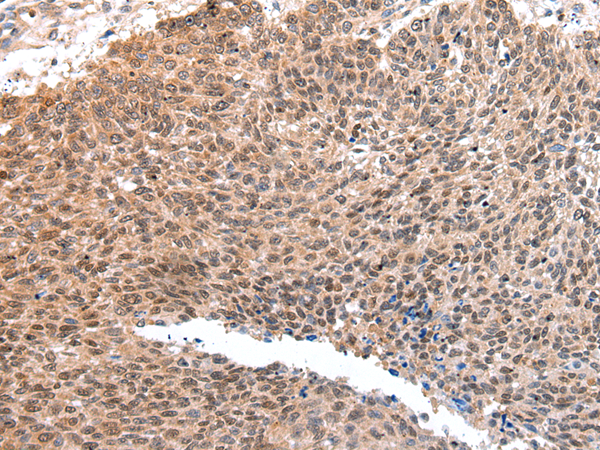

-
分类: 科研抗体货号: P12463别名: TREB36; EWS-ATF1; FUS/ATF-1应用: WB,IHC反应种属: Human, Mouse
-
分类: 科研抗体货号: P12446别名: SCELL应用: IHC反应种属: Human
-
分类: 科研抗体货号: P12480别名: MTLC应用: IHC反应种属: Human
-
分类: 科研抗体货号: P12462别名: AQP9; AQP7L; AQPap; GLYCQTL应用: IHC反应种属: Human
-
分类: 科研抗体货号: P12473别名: PC2; NBP16应用: WB反应种属: Human, Mouse
-
分类: 科研抗体货号: P12479别名: DEZ; RVER1; ChemR23; CHEMERINR应用: IHC反应种属: Human
-
分类: 科研抗体货号: P12461别名: CLI; AAG4; APOJ; CLU1; CLU2; KUB1; SGP2; APO-J; SGP-2; SP-40; TRPM2; TRPM-2; NA1/NA2应用: WB,IHC反应种属: Human
-
分类: 科研抗体货号: P12471别名: CTSO; PKND; PYCD; CTS02; CTSO1; CTSO2应用: IHC反应种属: Human, Mouse, Rat
-
分类: 科研抗体货号: P12478别名: HM5应用: IHC反应种属: Human, Mouse, Rat
-
分类: 科研抗体货号: P12460别名: C3-C5; METH1应用: IHC反应种属: Human, Mouse, Rat

鄂公网安备42018502007531号
鄂公网安备42018502007531号

